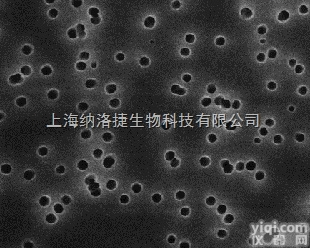
德国Lipoid GMBH <em>磷脂</em><em>氢化</em>大豆<em>磷脂</em>酰<em>胆碱</em>

3436-44-0 高纯氢化大豆磷脂,DDPC,合成磷脂酰胆碱PC
- 品牌:新研博美
- 型号:3436-44-0
- 产地:瑞士
- 供应商:陕西新研博美生物科技有限公司
- 供应商报价:面议
- 标签:高纯氢化大豆磷脂,DDPC,合成磷脂酰胆碱PC,-1,陕西新研博美生物科技有限公司
| 品牌 | 其他品牌 | 货号 | 3436-44-0 |
|---|---|---|---|
| 规格 | 1克/5克/10克/50克 | 供货周期 | 现货 |
| 主要用途 | 用于科研 |
高纯氢化大豆磷脂,DDPC,合成磷脂酰胆碱PC

陕西新研博美生物科技有限公司主要供应磷酸甘油脂(glycerolphospholiid)和鞘磷脂(sphingolipid)。它们都是极性脂。极性脂由极性部分(叫做极性头)和非极性部分(叫做非极性尾)组成。其中,甘油磷脂又可以根据极性头部集团的不同区分为磷脂酰胆碱(Phosphatidyl cholines,PC)、磷脂酰乙醇胺(Phosphatidyl ethanolamines,PE)、磷脂酰丝氨酸(Phosphatidyl serines,PS)、磷脂酰肌醇(Phosphatidyl inositols,PI)、磷脂酰甘油(PG)、甘油磷脂酸(phosphatidic acid,PA)等。除此外,在甘油磷脂分子中甘油第1位的脂酰基被长链醇取代形成醚,如缩醛磷脂(plasmalogen)及血小板活化因子(platelet activating factor,PAF)等。

高纯氢化大豆磷脂(HSPC)Soybean Phospholipids Mixed compounds
英文名称:Hydrogenated Soybean Phospholipids,
Predominant compounds: 1-palmitoyl-2-stearoyl-sn-glycero-3-phosphatidylcholine (>98%)
中文名称:高纯氢化大豆卵磷脂;
主要成分:1-棕榈酰基-2-硬脂酰基卵磷脂(>98%)
HSPC IUPAC命名:Predominant compounds: 1-palmitoyl-2-stearoyl-sn-glycero-3-phosphocholine
纯度:>99%
储存:-20°
供应商:陕西新研博美生物科技有限公司
二癸酰基卵磷脂DDPC|3436-44-0
英文名称:Didecanoyl Phosphatidylcholine
中文名称:二癸酰基卵磷脂
别 名:1, 2-didecanoyl-sn-glycero-3-phosphocholine
CAS号:3436-44-0
分子量:565.7
结构式:
纯度:>99%
储存:-20°
供应商:陕西新研博美生物科技有限公司
二月桂酰基卵磷脂DLPC
陕西新研博美生物科技有限公司是国内专业供应磷脂、油脂、脂类和聚乙二醇衍生试剂的公司,产品主要应用于脂质体、纳米靶向试剂等。
产品信息:
DLPC中文名:二月桂酰基卵磷脂
英文名:DLPC
DLPC:1,2-dilauroyl-sn-glycero-3-phosphocholine
CAS号:18194-25-7
货号:LP-R4-101
纯度:大于99%
包装:1克/10克
价格:面议
货期:现货
储存:-20°
供应商:陕西新研博美生物科技有限公司

合成磷脂酰胆碱PC类
合成磷脂DDPC Phosphatidylcholine
通用名称(英文):Didecanoyl Phosphatidylcholine
通用名称(中文):二癸酰基卵磷脂命名:1, 2-didecanoyl-sn-glycero-3-phosphocholine
CAS号:3436-44-0
分子量:565.7
合成磷脂DLPC Phosphatidylcholine
DLPC通用名称(英文):Dilauroyl Phosphatidylcholine
DLPC通用名称(中文):二月桂酰基卵磷脂
DLPC IUPAC命名:1,2-dilauroyl-sn-glycero-3-phosphocholine
DLPC CAS号:18194-25-7
DLPC分子量:621.8
合成磷脂 DAPC Phosphatidylcholine
DAPC通用名称(英文):Dieicosanoyl Phosphatidylcholine
DAPC通用名称(中文):二花生酰基卵磷脂,二花生酰基磷脂酰胆碱
DAPC IUPAC命名:1, 2- Dieicosanoyl -sn-glycero-3-phosphocholine
DAPCCAS号:61596-53-0
DAPC分子量:846.25
DAPC分子式:C48H96NO8P
合成磷脂DMPC Phosphatidylcholine
DMPC通用名称(英文):Dimyristoyl Phosphatidylcholine
DMPC通用名称(中文):二肉豆蔻酰基卵磷脂
DMPC IUPAC命名:1, 2-dimyristoyl-sn-glycero-3-phosphocholine
DMPC CAS号:18194-24-6
DMPC分子量:677.9
合成磷脂DOPC Phosphatidylcholine
DOPC通用名称(英文):Dioleoyl Phosphatidylcholine
DOPC通用名称(中文):二油酰基卵磷脂
DOPC IUPAC命名:1, 2-dioleoyl-sn-glycero-3-phosphocholine
DOPC CAS号:4235-95-4
DOPC分子量:786.1
合成磷脂DPPC Phosphatidylcholine
DPPC通用名称(英文):Dipalmitoyl Phosphatidylcholine
DPPC通用名称(中文):二棕榈酰基卵磷脂
DPPC IUPAC命名:1, 2-dipalmitoyl-sn-glycero-3-phosphocholine
DPPC CAS号:63-89-8
DPPC分子量:734.0
合成磷脂DSPC Phosphatidylcholine
DSPC通用名称(英文):Distearoyl Phosphatidylcholine
DSPC通用名称(中文):二硬脂酰基卵磷脂
DSPC IUPAC命名:1, 2-distearoyl-sn-glycero-3-phosphocholine
DSPC CAS号:816-94-4
DSPC分子量:790.2
合成磷脂POPC Phosphatidylcholine
POPC通用名称(英文):1-palmitoyl-2-oleoyl-sn-glycero-3-phosphocholine
POPC 通用名称(中文):1-棕榈酰基-2-油酰基卵磷脂
POPC IUPAC命名:1-palmitoyl-2-oleoyl-sn-glycero-3-phosphocholine
POPC CAS号:26853-31-6
POPC 分子量:760.1
合成磷脂SMPC Phosphatidylcholine
SMPC通用名称:1-stearoyl-2-myristoyl-sn-glycero-3-phosphatidylcholine
SMPC 通用名称(中文):1-硬脂酰基-2-肉豆蔻酰基卵磷脂
SMPC IUPAC命名:1-stearoyl-2-myristoyl-sn-glycero-3-phosphatidylcholine
SMPC CAS号:20664-02-2
SMPC 分子量:734.0
合成磷脂DEPC Phosphatidylcholine
DEPC通用名称(英文):Dierucoyl Phosphatidylcholine
DEPC通用名称(中文):二芥酰基卵磷脂
DEPC IUPAC命名:1, 2-dierucoyl-sn-glycero-3-phosphocholine
DEPC CAS号:51779-95-4
DEPC分子量:898.3
合成磷脂MPPC Phosphatidylcholine
MPPC通用名称(英文):1-myristoyl-2-palmitoyl-sn-glycero-3-phosphatidylcholine
MPPC通用名称(中文):1-肉豆蔻酰基-2-棕榈酰基卵磷脂
MPPC IUPAC命名:1-myristoyl-2-palmitoyl-sn-glycero-3-phosphocholine
MPPC CAS号:69525-80-0
MPPC分子量:706.0
合成磷脂MSPC Phosphatidylcholine
MSPC通用名称:1-myristoyl-2-stearoyl-sn-glycero-3-phosphatidylcholine
MSPC通用名称(中文):1-肉豆蔻酰基-2-硬脂酰基卵磷脂
MSPC IUPAC命名:1-myristoyl-2-stearoyl-sn-glycero-3-phosphocholine
MSPC CAS号:
MSPC分子量:734.0
合成磷脂PMPC Phosphatidylcholine
PMPC通用名称:1-palmitoyl-2-myristoyl-sn-glycero-3-phosphatidylcholine
PMPC 通用名称(中文):1-棕榈酰基-2-肉豆蔻酰基卵磷脂
PMPC IUPAC命名:1-palmitoyl-2-myristoyl-sn-glycero-3-phosphocholine
PMPC CAS号:63119-37-9
PMPC分子量:706.0
合成磷脂PSPC Phosphatidylcholine
PSPC通用名称:1-palmitoyl-2-stearoyl-sn-glycero-3-phosphatidylcholine
PSPC 通用名称(中文):1-棕榈酰基-2-硬脂酰基卵磷脂
PSPC IUPAC命名:1-palmitoyl-2-stearoyl-sn-glycero-3-phosphocholine
PSPC CAS号:59403-51-9
PSPC 分子量:762.1
合成磷脂SPPC Phosphatidylcholine
SPPC通用名称:1-stearoyl-2-palmitoyl-sn-glycero-3-phosphatidylcholine
SPPC 通用名称(中文):1-硬脂酰基-2-棕榈酰基卵磷脂
SPPC IUPAC命名:1-stearoyl-2-palmitoyl-sn-glycero-3-phosphatidylcholine
SPPC CAS号:59403-53-1
SPPC 分子量:762.1
合成磷脂MOPC Phosphatidylcholine
MOPC通用名称:1-myristoyl-2-oleoyl-sn-glycero-3-phosphatidylcholine
MOPC 通用名称(中文):1-肉豆蔻酰基-2-油酰基卵磷脂
MOPC IUPAC命名:1-myristoyl-2-oleoyl-sn-glycero-3-phosphatidylcholine
MOPC CAS号:80863-06-5
MOPC分子量:732.0
合成磷脂SOPC Phosphatidylcholine
SOPC通用名称(英文):1-stearoyl-2-oleoyl-sn-glycero-3-phosphocholine
SOPC 通用名称(中文):1-硬脂酰基-2-油酰基卵磷脂
SOPC IUPAC命名:1-stearoyl-2-oleoyl-sn-glycero-3-phosphocholine
SOPC CAS号:56421-10-4
SOPC 分子量:788.1
合成磷脂 PLPC Phosphatidylcholine
PLPC通用名称(英文):1-palmitoyl-2-lauroyl-phosphatidylcholine
PLPC通用名称(中文):1-棕榈酰-2-月桂酰-sn-甘油-3-磷酸胆碱
PLPC IUPAC命名:1- palmitoyl--2-lauroyl- sn-glycero-3-phosphocholine
PLPCCAS号:
PLPC分子量:727.986
PLPC分子式:C36H72NO8P
合成磷脂DPePC, Chloride Phosphatidylcholine
DPePC Chloride通用名称(英文):Dipalmitoyl ethylphosphatidylcholine chloride salt
DPePC Chloride通用名称(中文):1,2-二棕榈酰-sn-甘油-3-乙基磷酸胆碱,氯盐
DPePC Chloride IUPAC命名:1,2-dipalmitoyl-sn-glycero-O-ethyl-3-phosphocholine,chloride
DPePC Chloride CAS号:328250-18-6
DPePC Chloride分子量:798.553
DPePC Chloride分子式:C42H85NO8PCl
合成磷脂DPePC, Triflate Phosphatidylcholine
DPePC Chloride通用名称(英文):Dipalmitoyl ethylphosphatidylcholine Tf salt
DPePC Chloride通用名称(中文):1,2-二棕榈酰-sn-甘油-3-乙基磷酸胆碱,三氟甲磺酸盐
DPePC Chloride IUPAC命名:1,2-dipalmitoyl-sn-glycero-O-ethyl-3-phosphocholine, Triflate
DPePC Chloride CAS号:474945-32-9
DPePC Chloride分子量:
DPePC Chloride分子式:C43H85NO11PSF3
高纯氢化大豆磷脂,DDPC,合成磷脂酰胆碱PC